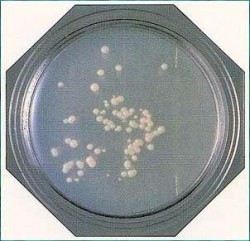
Clean Stamp NTG

Clean Stamp NTG
- Producător:Japonia
SCD Agar cu Lecitina, Polisorbat 80
Placa RODAC pentru testare NTG
Cu agent inactivator
Clean Stamp este un agar preparat, cu o suprafata de 25 cm2, destinat testarii aeroflorei si suprafetelor, atunci cind standardele impun o suprafata mai mare de contact.
Pentru aeroflora se lasa placa cu capacul desfacut in mediul de testat timp de 30 minute, apoi se incubeaza.
Pentru suprafete se stampileaza o singura data suprafata de testat si se incubeaza.
Incubati la 35℃ timp de 24 - 48 ore
Vizualizări produs: 2253
Solicită informații sau comandă produsul:
Atenție: toate câmpurile sunt obligatorii.